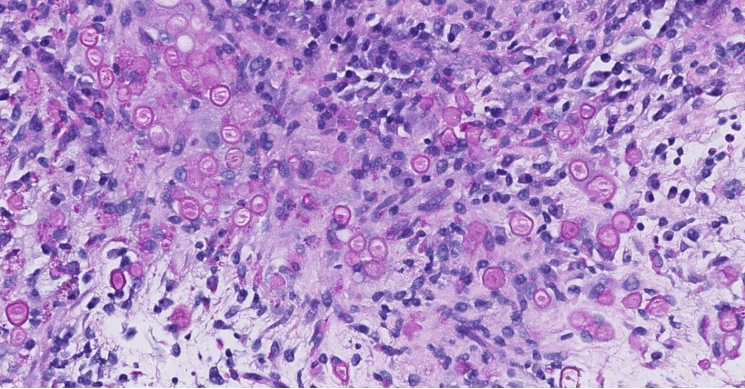

MAY 2026
Authors: Brigiet Hoevenaars, MD¹; Geert van Leenders, MD, PhD²
¹ Department of Pathology, Canisius Wilhelmina hospital, Nijmegen, The Netherlands, ² Department of Pathology, Erasmus MC, Rotterdam, The Netherlands
A 61-year-old patient underwent PET-CT imaging for staging of muscle-invasive urothelial carcinoma of the bladder. Imaging demonstrated an intensely hypermetabolic lesion located dorsally to the right kidney at the level of the Gerota fascia. The lesion was not clearly separable from the renal parenchyma.
A percutaneous core needle biopsy of the renal lesion was performed.
Microscopic findings
- Fibroadipose tissue with a dense chronic inflammatory infiltrate composed predominantly of lymphocytes, plasma cells and numerous histiocytes, with scattered neutrophils.
- Multiple variably sized, rounded concentric structures strongly positive on DPAS staining and with a central dot-like core or a laminated configuration.
- No cytologic atypia or malignant epithelial component was identified.
Immunohistochemical and Histochemical findings
- CD68 highlighted numerous histiocytes within the inflammatory infiltrate.
- Ker AE1/AE3 was negative.
- DPAS: positive concentric structures
- Grocott: negative
- Von Kossa: negative

Figure 1. HE

Figure 2. HE

Figure 3. HE
Figure 4. DPAS

Figure 5. Grocott

Figure 6. van Kossa
Test yourself. What diagnosis would you give to this case?
- Malakoplakia
- Parasitic infection
- Chronic lymphohistiocytic inflammation with Liesegang rings
- Metastatic urothelial carcinoma
- Renal cell carcinoma with calcifications
Diagnosis by author:
Chronic lymphohistiocytic inflammation with Liesegang rings
Discussion of case
Liesegang rings are rare concentric laminated structures that can occur in cystic or inflammatory conditions and represent periodic precipitation of organic material. Although most frequently described in cysts and inflammatory lesions of the genitourinary tract, they are rarely encountered in renal biopsies. This patient had a long-standing history of urethral strictures since 1994 associated with chronic obstructive voiding symptoms. Chronic urinary obstruction and recurrent urinary tract infections may contribute to persistent inflammatory changes in the urinary tract, which could provide a setting for the development of Liesegang rings.
Histologically, Liesegang rings appear as variably sized round structures with a laminated or ring-like configuration and may contain a central dense core. This pattern might result from alternating precipitation and diffusion of supersaturated solutions around a central amorphous nidus. They are typically PAS or DPAS positive and negative for calcium stains such as Von Kossa, helping to distinguish them from calcified structures.
In renal tissue, Liesegang rings may be associated with chronic inflammatory processes, including cystic lesions and xanthogranulomatous pyelonephritis. Their presence can lead to diagnostic confusion with parasitic organisms, psammoma bodies, or Michaelis–Gutmann bodies of malakoplakia.
In the present case, the radiologic finding of a PET-avid renal mass raised concern for metastatic disease or primary renal malignancy. However, histologic examination demonstrated a chronic lymphohistiocytic inflammatory process without evidence of malignancy. The presence of DPAS-positive concentric structures with negative Grocott and Von Kossa staining favored Liesegang rings rather than parasitic structures or malakoplakia.
Recognition of this rare phenomenon is important to avoid overinterpretation as infection or malignancy, particularly in small biopsy specimens obtained from radiologically suspicious lesions.
Key differential diagnosis
Malakoplakia
- Michaelis–Gutmann bodies
- Von Kossa positive
- CD68 positive macrophages
Parasitic ova
- Identifiable parasitic structures
- Grocott positive in some organisms
- Van Kossa negative
Psammoma bodies / Renal calculi
- Concentrically laminated calcifications
- Von Kossa positive
- DPAS negative
Xanthogranulomatous pyelonephritis
- CD68 positive foamy macrophages
- chronic inflammation
- may rarely contain Liesegang rings
References
[1] Naresh Bharti J, Bharti S, Singh Nigam J. Liesegang rings in kidney diseases- A Systematic Review. Curr Med Imaging. 2023 Aug 17. Epub ahead of print. PMID: 37594156.
[2] Pegas KL, Edelweiss MI, Cambruzzi E, Zettler CG. Liesegang rings in xanthogranulomatous pyelonephritis: a case report. Patholog Res Int. 2010 Jan 4;2010:602523. PMID: 21151725; PMCID:
[3] Vizcaíno, J.R., Macedo-Dias, J.A., Teixeira-de-Sousa, J.M., Silva, R.M. and Carpenter, S. (2005), Pseudotumour of renal pelvis: Liesegang rings mimicking a solid neoplasm of the renal pelvis. Histopathology, 47: 115-117.